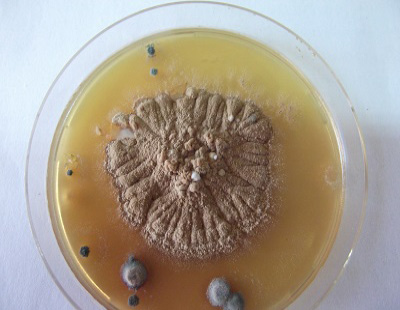
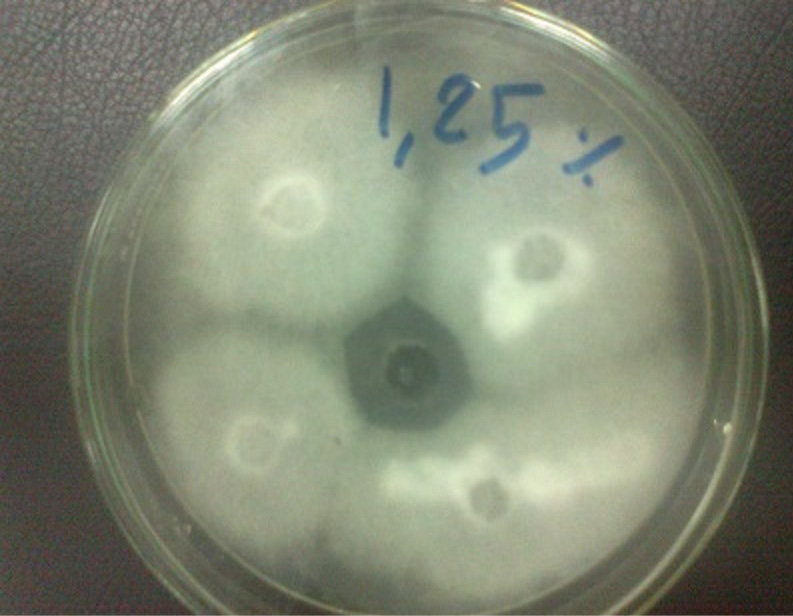
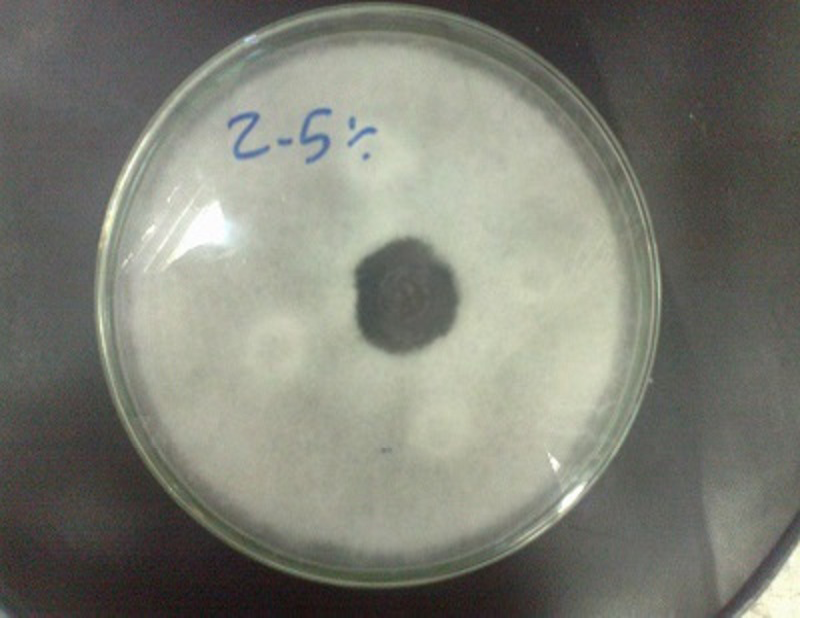
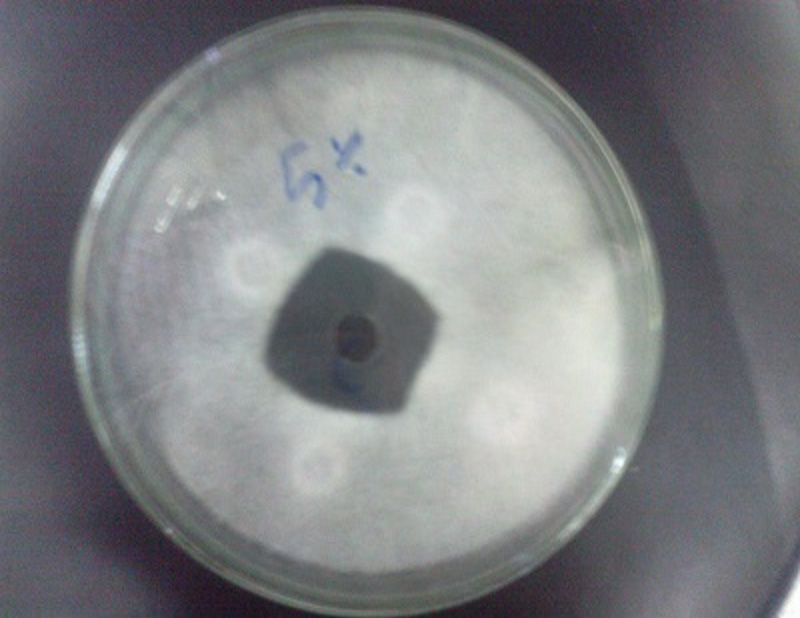

Advances in Animal and Veterinary Sciences
Ring worm lesions of face, neck and body of a calf
Typical ring worm lesions on the body of a calf
Typical ring worm lesions on the head of a calf
Trichophyton verrucosum growth on sabaroude dextrose agar
Trichophyton verrucosum grow on potato dextrose agar and shown antifungal activity bergamot 1.25% with zone of inhibition 28 mm
Trichophyton verrucosum grow on potato dextrose agar and shown antifungal activity bergamot 2.5% with zone of inhibition 32 mm
Trichophyton verrucosum grow on potato dextrose agar and shown antifungal activity bergamot 5% with zone of inhibition 40 mm